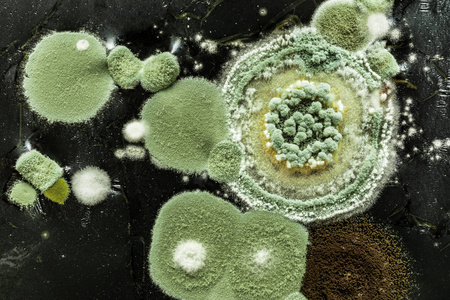
可能是由污垢病毒霉菌或细菌引起的.

霉菌病毒图片

霉菌是什么 霉菌病毒的介绍
图片尺寸400x294
(霉菌在电子显微镜下的性状)
图片尺寸640x487
太恐怖原来我们的汽车空调系统里住着霉菌尘螨细菌真菌等一大家子
图片尺寸944x642
超清晰疫霉果腐病病原图片
图片尺寸690x520
农作物苦瓜,连续下雨后长霉菌,大家帮忙看下这是什么霉菌,应该用什么
图片尺寸1080x1456
曲霉菌病
图片尺寸819x614
请各位进来看下这具体是什么霉菌.
图片尺寸3648x2736
着色芽生菌病暗色孢科真菌感染
图片尺寸638x773
可能是由污垢病毒霉菌或细菌引起的.
图片尺寸450x300
为什么说牧霉清控制鸡腹泻的效果好
图片尺寸1080x720
霉菌是什么(霉菌)
图片尺寸1200x797
什么是霉菌
图片尺寸700x350
教科版四年级下册科学,第三单元,面包发霉了 显微镜下的霉菌 孢子囊
图片尺寸1080x810
小心你家的「霉菌」跑进身体!
图片尺寸1200x620
霉菌mould
图片尺寸1280x853
被宠坏的腐烂卷心菜与霉菌霉菌病毒图标绿色矢量青黄色圆霉菌在黑色
图片尺寸300x300
酵母菌和霉菌
图片尺寸1080x810
应该怎么解决? 诺福消毒剂帮您解决霉菌超标问题-润联环保
图片尺寸1080x591
灰指甲和手足癣的真菌长什么样
图片尺寸1080x691
曲霉菌病
图片尺寸819x614